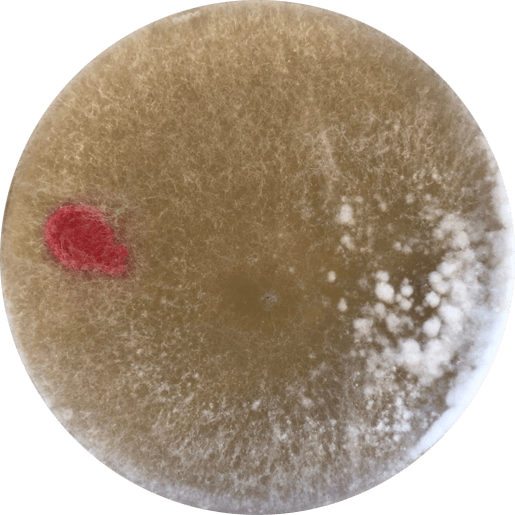
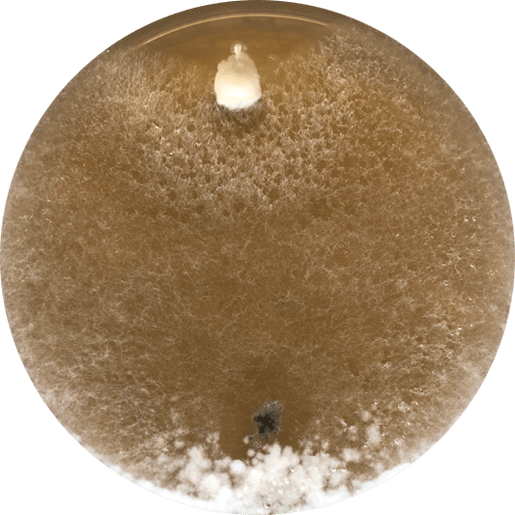
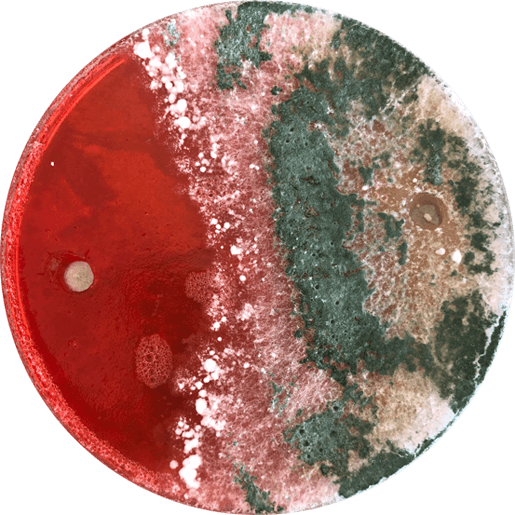

Seed Treatment
Biological Seed treatments are here to protect the future of farming.
As chemical active ingredients are removed from the market globally, growers need effective ways to protect their seed and grow crops more sustainably.
Agrimm manufacture a range of seed treatments that produce cost-effective and repeatable results whether applied on -farm or by commercial seed coating companies.

Why should you use them?
Biological seed treatments fill a gap that other chemistry cannot fill, because they offer dynamic interactions in the rootzone. Crop management does not start with the first spray pass, in fact by using biological seed treatments, you can build a biological bridge between planting and spraying.
What can you expect?
We focus on using the best strains of endophytic Trichoderma to:
- Promote early Root and Foliar Growth
- Get the crop out of the ground faster and with a greater root biomass. This produces stronger healthier plants that can cope with environmental stresses.
- Improve nutrient uptake.
- The action of Trichoderma in and around the roots increases both the amount of plant available nutrients, and the roots’ efficiency to uptake them.
- Stimulate a systemic response in the plant.
- Endophytic Trichoderma trigger the defence mechanism of the plant, priming its faculties and raising photosynthetic performance.


We focus on using the best strains of endophytic Trichoderma to:

Promote early root and foliar growth
Get the crop out of the ground faster and with a greater root biomass. This produces stronger healthier plants that can cope with environmental stresses.

Improve nutrient uptake
The action of Trichoderma in and around the roots increases both the amount of plant available nutrients, and the roots’ efficiency to uptake them.

Stimulate a systemic response in the plant
Endophytic Trichoderma trigger the defence mechanism of the plant, priming its faculties and raising photosynthetic performance.

Compatible with conventional fungicides and insecticides
At Agrimm, we test our seed treatments both with and without chemical alternatives. Our products provide excellent protection and have demonstrated solid yield benefits when used on their own, often exceeding conventional chemical treatments.
However, we do understand that some growers may prefer a more “belt and braces” approach and so we test the compatibility of our Trichoderma with chemical active ingredients, both in suspension and on seed.
Our findings, like others in the industry, are that:
“Agrimm seed treatments are not killed by fungicides.”
Why is this?
- Our method of production produces robust Trichoderma spores which are resistant to fungicides.
- Seed applied Trichoderma grows out into the soil from the seed. Fungicides operate in a more local environment, and the mycelial growth of the Trichoderma follows the root exudates, operating in and influencing a far greater space than where originally applied.
We believe that the choice should no longer be an either / or approach to biological and conventional – but can also be Biological and Conventional.

Plates show mycelial growth and production of conidia across a well of pure chemical active ingredient.



